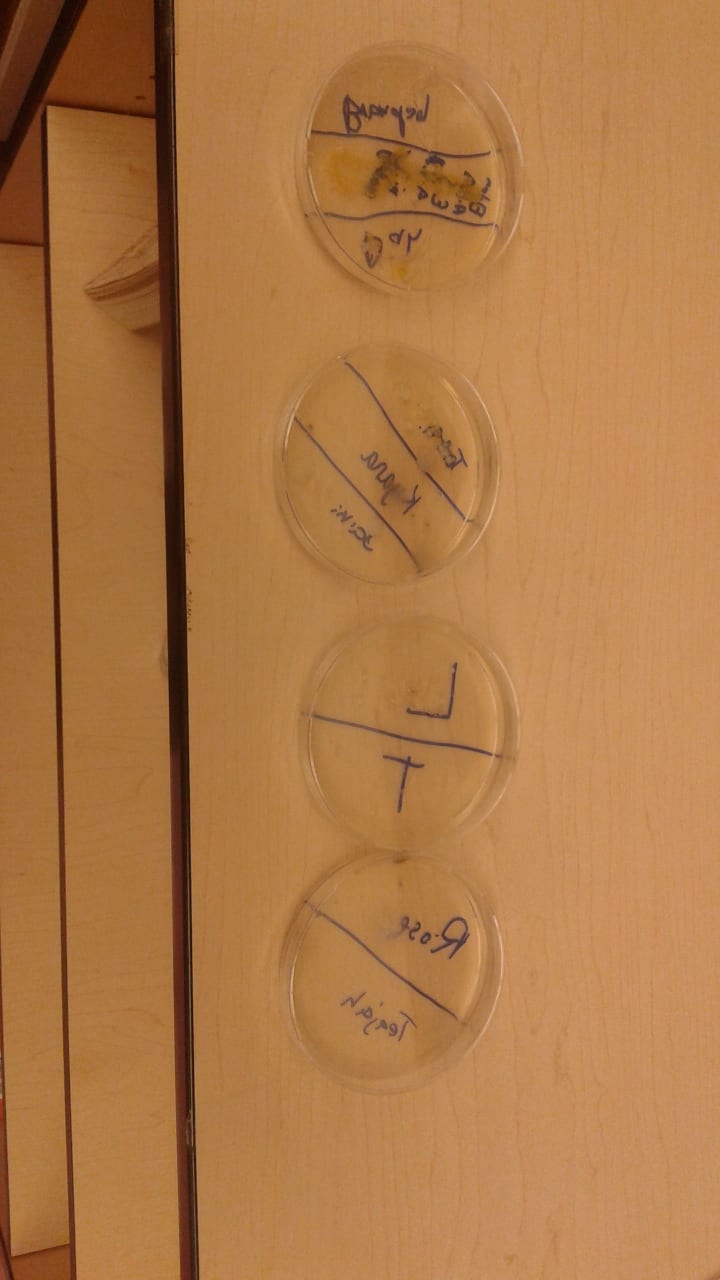

This October, students at Austin College and Career Academy learned what it means to be alive, growing and adapting! We studied how plants grow from a seed. We wanted to see how different factors affected growth, so we put our plants through a number of interesting tests. One
This October, students at Austin College and Career Academy learned what it means to be alive, growing and adapting! We studied how plants grow from a seed. We wanted to see how different factors affected growth, so we put our plants through a number of interesting tests. One  student wanted to know if ketchup and mustard put in the soil changes how grass grows, and so we found out! But we didn’t stop there! Did you know bacteria and fungi, like the the mold that grows on old bread is alive? In order to find a what kinds of microbes live in our building, we used agar plates to harvest samples from the school. Surprisingly, the dirtiest place is the dusty corners of the classroom and not the bathroom! “That’s what is on our floors?! I just swept here! Next time I drop food, the floor can have it!” said one student. Finally, we discussed the importance of finding food, and not becoming food with our food web games. Students
student wanted to know if ketchup and mustard put in the soil changes how grass grows, and so we found out! But we didn’t stop there! Did you know bacteria and fungi, like the the mold that grows on old bread is alive? In order to find a what kinds of microbes live in our building, we used agar plates to harvest samples from the school. Surprisingly, the dirtiest place is the dusty corners of the classroom and not the bathroom! “That’s what is on our floors?! I just swept here! Next time I drop food, the floor can have it!” said one student. Finally, we discussed the importance of finding food, and not becoming food with our food web games. Students learned about the interactions of animals from our own back yards, South America, and Africa. We studied the effects of wolves on the environment in Yellowstone National Park and then experienced what it was like to be a hunter or hunted in our own custom version of Tag!
learned about the interactions of animals from our own back yards, South America, and Africa. We studied the effects of wolves on the environment in Yellowstone National Park and then experienced what it was like to be a hunter or hunted in our own custom version of Tag! 
Written by: Kyle Reid
